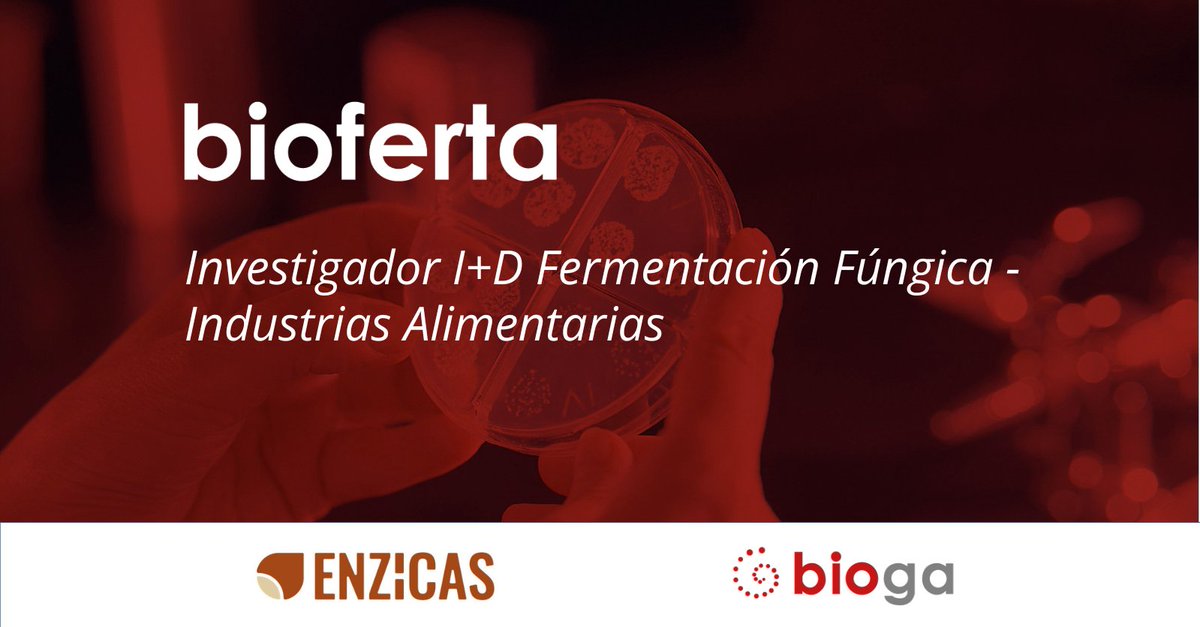
BIOGA tweet media

BIOGA retweetledi

📢 El @CDTI_innovacion participa en @galiciabiodays 2026, la 3ª edición del foro de referencia en #biotecnología y ciencias de la vida en el Espacio Atlántico Europeo informando sobre las #AyudasCDTI para impulsar la I+D+i empresarial en el sector
ℹ️ eventos.cdti.es/agenda/2026050…
🗓️ 6-7 de MAYO | 📍Vigo
@BiogaCluster
#AyudandoCrearFuturo

Español